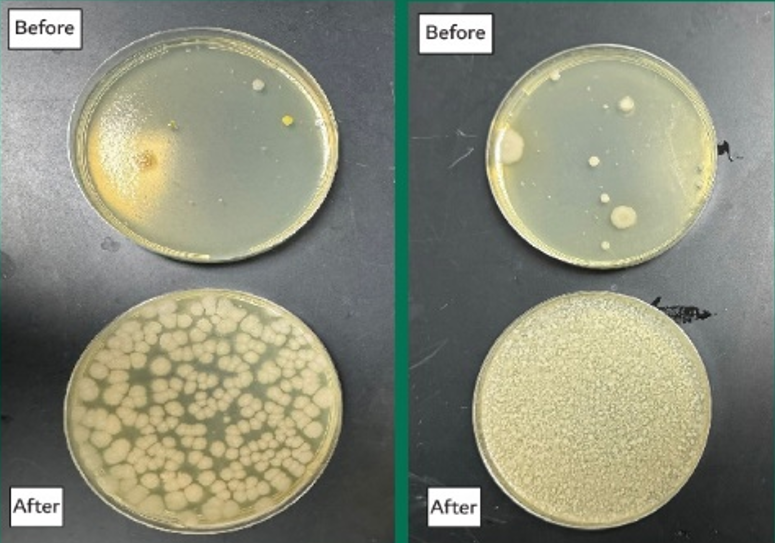

- Your cart is empty Browse Shop


We take pride in providing top-quality services.
BioBloomX is a next-generation bio-fertilizer company.
BioBloomX
BioBloomX is a next-generation bio-fertilizer company dedicated to transforming agriculture through science and sustainability. We specialize in microbial solutions that activate soil health, reduce chemical dependency, and help farmers achieve higher yields with fewer resources.
Our Mission
To empower farmers with innovative, science-driven biofertilizer solutions that enrich the soil, conserve water, and produce healthier, higher-quality crops — while protecting the environment for future generations.
Our Vision
To be a global leader in sustainable agriculture, helping communities worldwide shift from conventional farming to eco-friendly practices that balance productivity with responsibility.

At BioBloomX, we harness the natural power of beneficial microbes to:
- Increase crop productivity by up to 20%
- Save water by improving soil retention
- Reduce fertilizer use by up to 30%
- Strengthen plant immunity and resistance
- Improve crop quality and shelf life
Our products are fully organic, eco-friendly, and designed to work in harmony with nature’s own systems.
- Science-driven innovation backed by real results
- Smart, sustainable solutions combining the best of nature and science.
- Sustainable practices that reduce waste and costs
- Commitment to farmers, communities, and the planet
Founded with a vision to make farming smarter and greener, BioBloomX is more than a product — it’s a movement towards regenerative agriculture. From lab research to fields across the region, we are proud to support farmers in creating harvests that are not only abundant but also sustainable.
Registration No: F00006985
The BioBloomX difference is visible from the ground up. Our microbial innovation restores depleted soil into a living, nutrient-rich ecosystem — building a stronger for healthier crops and higher yields.
Cart (0 items)
BioBloomX is a microbial bio-fertilizer that transforms agriculture by revitalizing soil, improving crop health, and reducing the need for chemicals.
Contact Us
info@biobloomx.com
Email us:
Alzahraa Dist. Jeddah – Saudi Arabia
Location:
+966 554 661 916
Phone:
This site is registered on wpml.org as a development site. Switch to a production site key to remove this banner.

